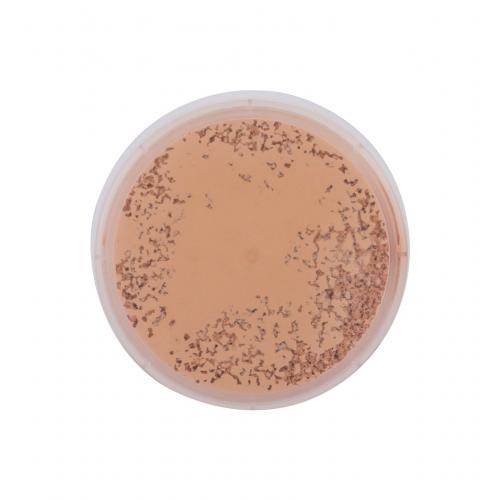

Cumpără Physicians Formula Mineral Wear Cushion Foundation SPF50 14 ml fond de ten tester pentru femei Light/Medium

Physicians Formula Mineral Wear Cushion Foundation SPF50 14 ml fond de ten tester pentru femei Light/Medium. Physicians Formula Mineral Wear Cushion Foundation SPF50 Fond de ten pentru femei 14 ml Nuanţă Light/Medium tester